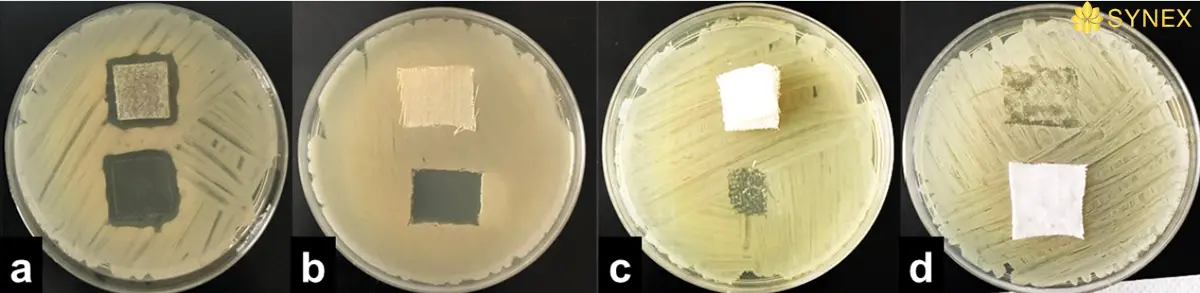
Quan sat ket qua thu nghiem tren dia
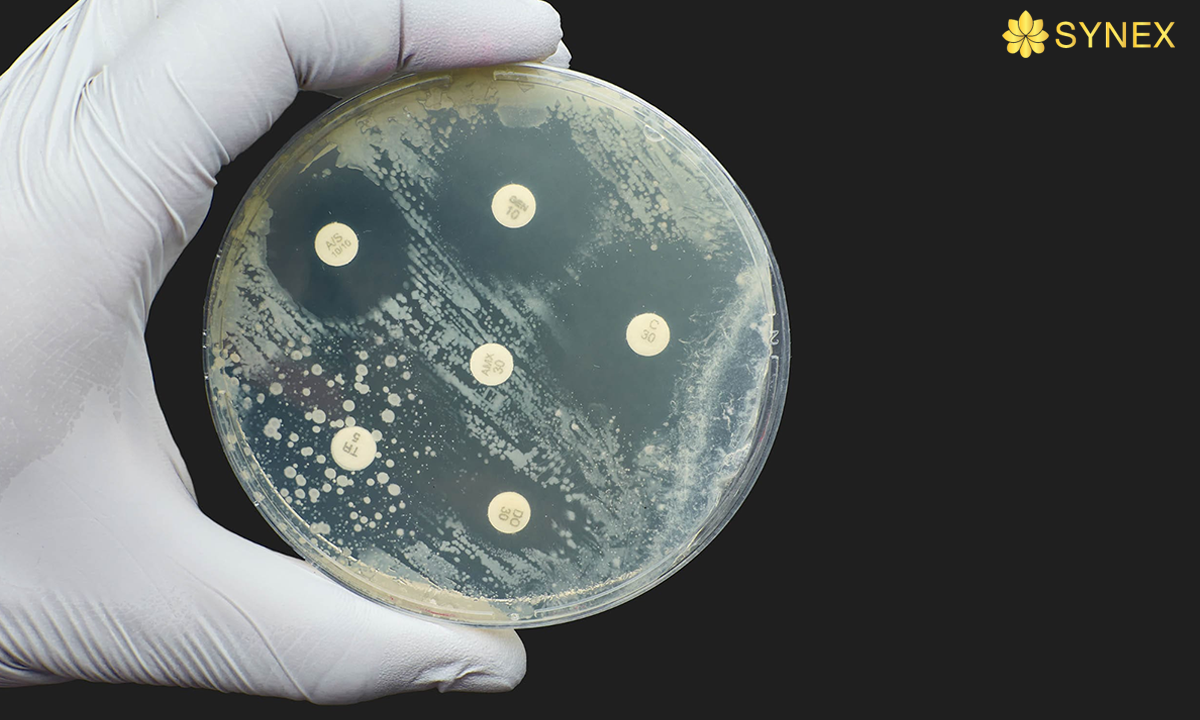
Kiem dinh vai khang khuan iso 20645
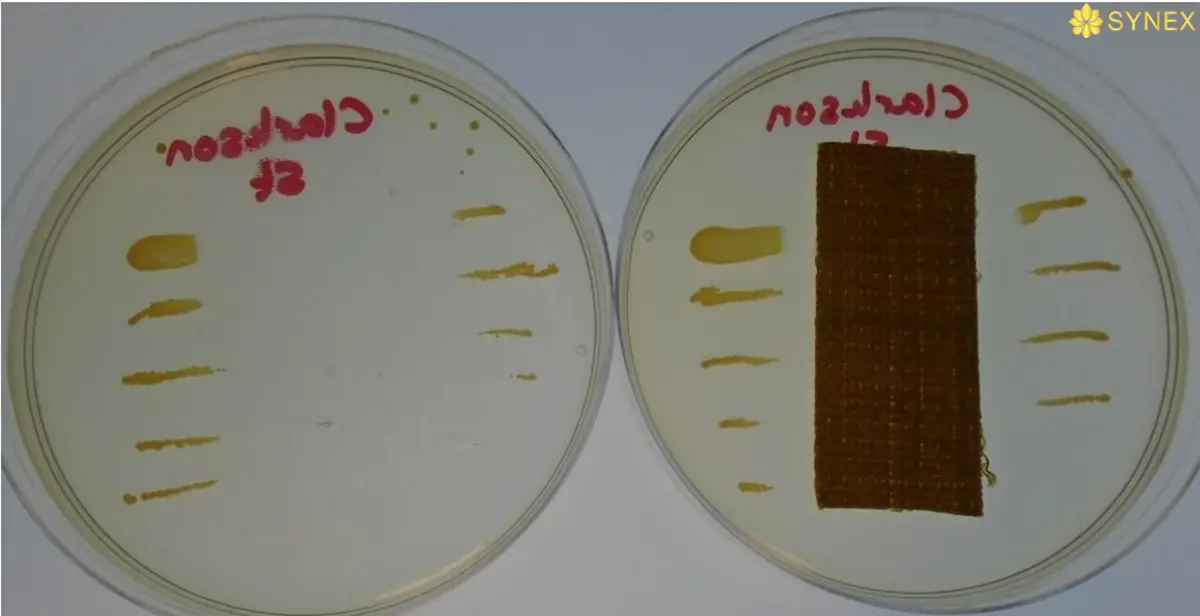
Mau thu da cay vi khuan staphylococcus
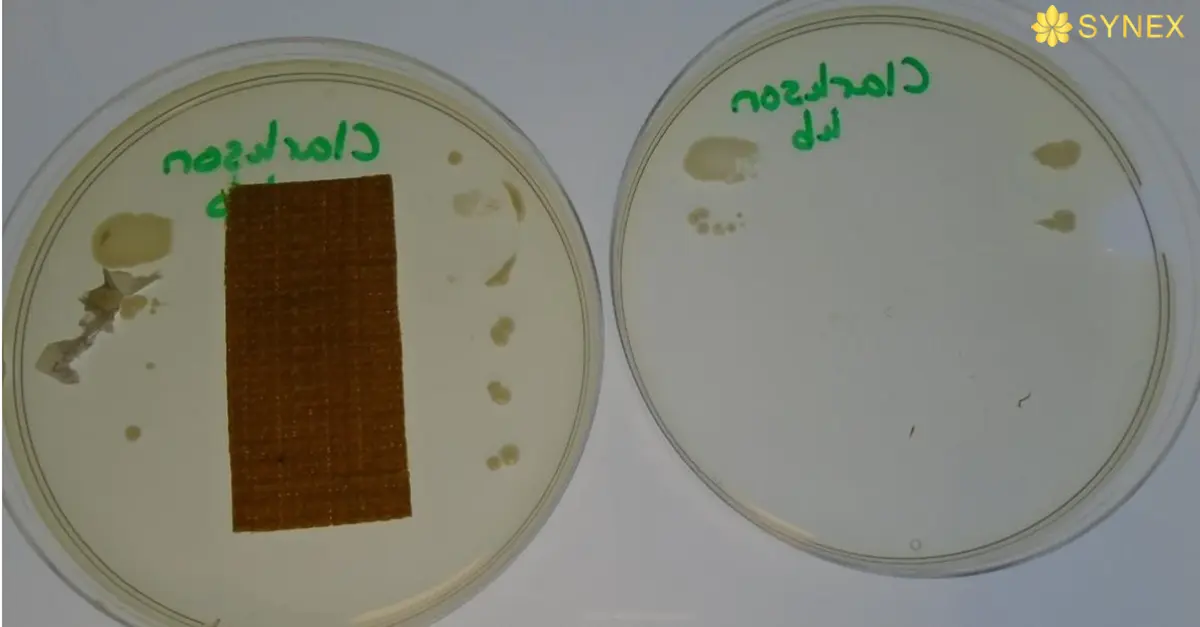
Mau thu da cay vi khuan Klebsiella 1

Bên cạnh quá trình sản xuất đòi hỏi sự kiểm soát nghiêm ngặt về chất lượng, việc thực hiện quy trình kiểm định vải kháng khuẩn cũng là bước cuối cùng không thể thiếu trước khi sản phẩm được đưa ra thị trường. Hãy cũng chúng tôi tìm hiểu quy trình kiểm định cũng như chứng nhận vải kháng khuẩn trong bài viết này nhé!

Tìm hiểu thêm: Vải tính năng kháng khuẩn khử mùi
Các Phương Pháp Kiểm Định Vải Kháng Khuẩn
Kiểm tra lớp hoàn thiện chống vi khuẩn trên vải dệt là một quy trình phức tạp hơn nhiều so với các loại kiểm tra khác. Dưới đây là một số phương pháp kiểm định vải kháng khuẩn thường được sử dụng nhất.
Một số sản phẩm vải tính năng synex tiêu chuẩn kháng khuẩn, khử mùi
Phương Pháp Agar Diffusion: ISO 20645

Nguyên tắc: Mẫu thử được đặt trên đĩa thạch hai lớp. Lớp dưới là môi trường nuôi cấy không vi khuẩn, lớp trên cấy các vi khuẩn đã chọn. Mức độ kháng khuẩn được đánh giá bằng cách kiểm tra mức độ phát triển của vi khuẩn trong vùng tiếp xúc giữa thạch và mẫu thử và, nếu có thì mức độ của vùng ức chế xung quanh mẫu vật như thế nào.
Thời gian thực hiện: 3-4 tuần
Các chủng vi khuẩn:
- Staphylococcus aureus (ATCC 6538 hoặc NCCB 46064),
- Escherichia coli (ATCC 11229 hoặc NCCB 1500)
- Klebsiella pneumoniae (ATCC 4352 hoặc NCCB 89160).
Thành phần thạch nuôi cấy:
| pepton trypton | 15g |
| phyton pepton | 5g |
| natri clorua | 5g |
| thạch-thạch | 15g |
| nước cất | 1 000 ml |
Thành phần môi trường dinh dưỡng cho các chủng vi khuẩn thử nghiệm:
| pepton trypton | 17g |
| phyton pepton | 3g |
| natri clorua | 5g |
| di-kali hydro phosphate | 2,5g |
| đường dextrose | 2,5g |
| nước cất | 1 000 ml |
Quy trình thực hiện như sau: Gel dinh dưỡng chứa vi sinh vật được đổ lên đĩa petri và mẫu thử được đặt trên bề mặt của gel. Sau đó, toàn bộ đĩa được ủ trong điều kiện lý tưởng cho sự phát triển của vi khuẩn. Ngoài ra, chất cấy có thể được phun lên mẫu sau khi đã được đặt trên đĩa thạch. Đối với vi khuẩn, thời gian ủ là 18–24 giờ ở 37 °C; đối với nấm, thời gian ủ là từ 3–14 ngày ở 28°C, hoặc lên đến 4 tuần đối với các vật liệu như vải phủ PVC. Sau thời gian ủ, các mẫu sẽ được đánh giá bằng cách quan sát trực quan hoặc đánh giá sự giảm hiệu suất.
Đánh giá trực quan được thực hiện bằng cách so sánh sự phát triển của vi sinh vật trên đĩa, nơi không bị cản trở bởi vật liệu kháng khuẩn, với sự phát triển của chúng trên hoặc tiếp xúc với mẫu.
Có thể quan sát thấy sự giảm tốc độ tăng trưởng hoặc hoàn toàn không có sự tăng trưởng trên mẫu, hoặc xuất hiện vùng ức chế xung quanh mẫu, nơi chất diệt khuẩn đã khuếch tán vào gel và ngăn cản sự phát triển của vi sinh vật. Các vùng ức chế lớn: chúng chỉ ra rằng vật liệu đã có quá nhiều chất diệt khuẩn hoặc chất diệt khuẩn đang khuếch tán nhanh chóng và dễ dàng vào gel, một dấu hiệu cho thấy độ bền sẽ không tốt. Do các biến thể có thể xảy ra, các mẫu sẽ luôn được kiểm tra ít nhất bốn lần với các đối chứng để kiểm tra khả năng tồn tại của sinh vật. Cần phải cẩn thận để tránh bị nhiễm vi khuẩn hoặc nấm từ bên ngoài vào.
Phương pháp này là một cách rất nhanh chóng và tiết kiệm để đánh giá vật liệu. Nó rất linh hoạt và có thể được áp dụng cho nhiều trường hợp khác nhau:
- Thử nghiệm có thể sử dụng vi khuẩn, nấm đơn lẻ hoặc nuôi cấy hỗn hợp.
- Các loại vải có phủ, không phủ, có cellulosic hoặc không có cellulosic đều có thể được kiểm tra.
- Thạch muối khoáng có thể được sử dụng để đảm bảo nguồn cacbon duy nhất là vật liệu đang được thử nghiệm, và sự phát triển của vi sinh vật sẽ chỉ ra sự suy thoái của vật liệu.
Đánh giá theo tính giảm hiệu suất có thể thực hiện bằng cách đo độ bền kéo hoặc giảm trọng lượng, tuy nhiên phương pháp này không đánh giá được hết tất cả các loại vật liệu. Ví dụ, với vải nylon phủ polyurethane, nylon có thể không bị ảnh hưởng bởi các sinh vật, do đó độ bền kéo của vật liệu không bị thay đổi và sự giảm trọng lượng là rất nhỏ. Tuy nhiên, nấm tấn công polyurethane có thể dẫn đến nứt hoặc mất khả năng chống thấm.
Phương pháp đĩa agar, khi sử dụng vi khuẩn, dựa vào việc chất diệt khuẩn trên vật liệu cần thử nghiệm di chuyển hoặc khuếch tán vào gel thạch. Nếu tốc độ khuếch tán rất thấp, như với một số vật liệu phủ hoặc lớp chống thấm nước, có thể dẫn đến kết quả sai lệch, đặc biệt khi vi khuẩn phát triển trước khi chất diệt khuẩn có thời gian khuếch tán ra. Vấn đề này có thể được khắc phục bằng cách giữ mẫu đĩa ở 50°C trong 24 giờ trước khi ủ. Trong giai đoạn này, vi sinh vật không phát triển nhưng chất diệt khuẩn có nhiều thời gian để khuếch tán vào gel.
Phương pháp đường song song AATCC 147
AATCC 147 cung cấp phương pháp đánh giá định tính khả năng kháng khuẩn của vải dệt, phù hợp với các vật liệu không có lớp phủ ngăn cản sự khuếch tán của vi khuẩn.
Nguyên tắc: Mẫu vải thử được đặt trực tiếp lên bề mặt thạch agar đã được cấy sẵn vi khuẩn.

Các chủng vi khuẩn: Staphylococcus aureus hoặc Escherichia coli (E. coli) là hai loại vi khuẩn phổ biến. Tuy nhiên, tùy theo mục đích sử dụng cuối cùng của vật liệu, có thể chọn các chủng vi khuẩn khác.
Quy trình thực hiện như sau: Mẫu có kích thước 25mm x 50mm được đặt trên các đĩa chứa thạch vô trùng có chứa vi khuẩn. Đối với các bước còn lại, quy trình tương tự như ISO 20645.

Cách đánh giá được tính theo phương trình:
W=(T-D)/2
Trong đó:
- W: Chiều rộng vùng ức chế vi khuẩn (mm)
- T: Đường kính tổng cộng của mẫu thử và vùng ức chế (mm)
- D: Đường kính mẫu thử (mm)
Phương trình này là một cách đơn giản để ước tính hiệu quả kháng khuẩn. Để có kết quả định lượng rõ ràng hơn, các phương pháp kiểm tra khác như thử nghiệm vi khuẩn trên môi trường lỏng hoặc sử dụng các chỉ số sinh học khác có thể được kết hợp.
Quy trình kiểm định vải kháng khuẩn theo phương pháp AATCC
Phương pháp AATCC 100 cung cấp một đánh giá định lượng chính xác về khả năng kháng khuẩn của vải dệt, giúp xác định hiệu quả của các sản phẩm có tính năng chống vi khuẩn.
Theo quy trình, một mẫu vải có kích thước 1,9 inch sẽ được tiếp xúc với dung dịch vi khuẩn, sau đó được ủ trong 18-24 giờ ở nhiệt độ 37°C. Kết quả thử nghiệm sẽ được tính toán để so sánh tỷ lệ phần trăm vi khuẩn còn lại trên vải dệt đã xử lý kháng khuẩn với vải chưa qua xử lý nhưng có cấu trúc tương tự.
Công thức tính: 100*(B-A)/B=R
Trong đó:
- A: Số lượng vi khuẩn còn lại sau khi xử lý trên mẫu thử (sau một khoảng thời gian ủ với vi khuẩn).
- B: Số lượng vi khuẩn ban đầu (số lượng vi khuẩn trước khi xử lý, khi mẫu vải chưa qua bất kỳ phương pháp kháng khuẩn nào).
- R: Tỷ lệ phần trăm giảm số lượng vi khuẩn (hay tỷ lệ hiệu quả kháng khuẩn), biểu thị phần trăm vi khuẩn đã bị tiêu diệt hoặc ức chế sự phát triển.

Giả sử:
- Số lượng vi khuẩn ban đầu (B) là 100.000 vi khuẩn.
- Sau khi xử lý với vải kháng khuẩn, số lượng vi khuẩn còn lại (A) là 20.000 vi khuẩn.
Khi áp dụng công thức:
R=100×(100,000−20,000)/100,000=100×80,000/100,000=80%
Điều này có nghĩa là hiệu quả kháng khuẩn của vải là 80%, tức là 80% vi khuẩn đã bị tiêu diệt hoặc ức chế.
Tuy nhiên, phương pháp này cũng đối mặt với một số thách thức, như khả năng tái tạo kém và sự khác biệt giữa kết quả thử nghiệm và điều kiện thực tế. Để đảm bảo độ chính xác, việc đào tạo nhân viên phòng thí nghiệm đúng cách và tuân thủ nghiêm ngặt quy trình thử nghiệm là yếu tố then chốt giúp đạt được kết quả đáng tin cậy và phù hợp với tiêu chuẩn chất lượng.
Cách nhận biết vải đạt chuẩn kháng khuẩn
Bạn đang tìm vải phù hợp?
SYNEX tư vấn chọn vải theo GSM, màu sắc và tính năng. Gửi mẫu nhanh 3–5 ngày.
Kiểm Tra Nhãn Mác Và Chứng Nhận
Nhãn “Antibacterial” hoặc “Antimicrobial“: Những sản phẩm vải kháng khuẩn thường được dán nhãn hoặc ghi rõ trên bao bì rằng chúng có tính năng kháng khuẩn.

Chứng nhận quốc tế: Các chứng nhận uy tín như AATCC 147 (kiểm định khả năng kháng khuẩn của vải) hoặc ISO 20743 (tiêu chuẩn quốc tế về kháng khuẩn) có thể được dán trên sản phẩm để chứng minh tính kháng khuẩn của vải.
Chứng nhận OEKO-TEX Standard 100: Mặc dù chứng nhận này không trực tiếp nói về tính kháng khuẩn, nhưng sản phẩm đạt chứng nhận này có thể đảm bảo rằng vải không chứa các hóa chất độc hại, và đôi khi có thể bao gồm các chất kháng khuẩn an toàn.
Tìm hiểu thêm về: Vải tính năng, phân loại và ứng dụng vải tính năng trong may mặc

Kiểm Tra Thành Phần Vải
Vải bạc (Silver-infused fabrics): Một số loại vải kháng khuẩn được tẩm hoặc sợi vải có chứa bạc, do bạc có đặc tính kháng khuẩn tự nhiên. Bạn có thể tìm thấy nhãn như “Silver-embedded” hoặc “Silver-ion treated” trên sản phẩm.
Vải đồng (Copper-infused fabrics): Đồng cũng có tính kháng khuẩn. Những loại vải này có thể ghi rõ là “Copper-infused” hoặc “Copper-treated”.
Vải tre (Bamboo fabrics): Vải làm từ sợi tre tự nhiên thường có khả năng kháng khuẩn nhẹ. Tuy nhiên, cần lưu ý rằng chỉ có những sản phẩm được xử lý đặc biệt mới có tính kháng khuẩn mạnh mẽ.
Các thương hiệu vải kháng khuẩn hiện nay
Thương hiệu Uniqlo
Uniqlo có dòng sản phẩm quần áo kháng khuẩn và khử mùi, sử dụng công nghệ “Anti-bacterial” và “AIRism”. Các sản phẩm này giúp giữ cho người mặc cảm thấy khô thoáng và sạch sẽ, đặc biệt là trong các điều kiện thời tiết nóng bức.
Thương hiệu Lululemon
Lululemon là thương hiệu thể thao nổi tiếng với các sản phẩm quần áo tập luyện. Nhiều sản phẩm của họ được làm từ vải kháng khuẩn giúp ngăn ngừa vi khuẩn gây mùi và giữ cho người mặc cảm giác thoải mái.
Thương hiệu Saxx
Saxx nổi bật với các sản phẩm đồ lót kháng khuẩn, giúp ngăn ngừa mùi hôi và tăng cường sự thoải mái cho người mặc. Thương hiệu này cũng chú trọng đến việc sử dụng các công nghệ vải đặc biệt giúp giảm ma sát và mồ hôi.
Kết luận
Các phương pháp kiểm định như ISO 20645, AATCC 147 và AATCC 100 đóng vai trò thiết yếu trong việc xác nhận và đánh giá chính xác khả năng kháng khuẩn của vải. Những kiểm định này không chỉ đảm bảo các sản phẩm dệt may đáp ứng các tiêu chuẩn an toàn và bảo vệ sức khỏe, mà còn giúp nâng cao giá trị thương hiệu, tạo niềm tin vững chắc cho người tiêu dùng. Với cam kết không ngừng nghiên cứu và sáng tạo, Synex sẽ luôn nỗ lực phát triển các dòng sản phẩm kháng khuẩn tiên tiến, đáp ứng nhu cầu ngày càng cao của khách hàng và góp phần mang lại sự an toàn, bảo vệ cho người sử dụng trong mọi hoàn cảnh.




